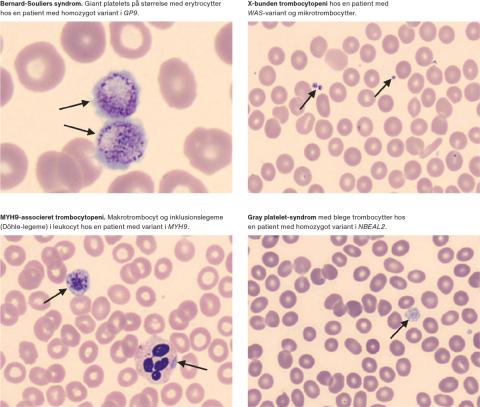
Eksempler på perifere udstryg ved forskellige arvelige trombocytsygdomme.

Arvelige trombocytsygdomme forårsages af genetiske varianter, der påvirker trombocytproduktionen eller trombocytternes funktion. De er en kompleks gruppe af sygdomme med varierende sværhedsgrad og symptombillede og er generelt overset i klinikken [1]. Her gennemgås baggrunden for de arvelige trombocytsygdomme samt deres udredning og håndtering.
-
Arvelige trombocytsygdomme er en heterogen sygdomsgruppe, som ofte er overset i klinikken.
-
Arvelige trombocytsygdomme kan være forbundet med syndromer eller andre sygdomme, og derfor er korrekt diagnostik vigtig.
-
Indførelsen af helgenomsekventering har øget vores viden og forbedret diagnostikken betydeligt.
-
Arvelige trombocytsygdomme er en heterogen sygdomsgruppe, som ofte er overset i klinikken.
-
Arvelige trombocytsygdomme kan være forbundet med syndromer eller andre sygdomme, og derfor er korrekt diagnostik vigtig.
-
Indførelsen af helgenomsekventering har øget vores viden og forbedret diagnostikken betydeligt.
Trombocyttens struktur og rolle i hæmostasen
Trombocytten er en yderst kompleks celle (Figur 1), der indgår i talrige fysiologiske funktioner og er afgørende for den hæmostatiske proces [2]. Trombocytter er kerneløse celler, der dannes fra megakaryocytter i knoglemarven ved frigivelse af cytoplasmafragmenter til blodbanen. Her cirkulerer trombocytterne langs med endotelet, så de er optimalt placerede, når der sker en skade på karvæggen. På skadestedet adhærerer de hurtigt til komponenter i den eksponerede ekstracellulære matrix (kollagen og von Willebrand-faktor) via transmembrane glykoproteinreceptorer, hvor de aktiveres og aggregerer til en primær prop.

En dobbeltlaget lipidmembran omgiver trombocytten, og ved aktivering dannes en prokoagulant overflade. Her akkumuleres blodets koagulationsfaktorer til tenase- og protrombinasekomplekserne (hhv. FVIIIa/FIXa og FXa/FVa), som resulterer i massiv dannelse af trombin, der omdanner tilstedeværende fibrinogen til et net af fibrintråde. Disse lejres omkring trombocytterne, hvor de krydsbindes, så trombocytproppen stabiliseres, og hæmostasen sikres [3]. Invaginationer af plasmamembranen danner trombocyttens åbne kanalikulære system, som er et komplekst anastomoserende netværk af membrankanaler, der understøtter transport af proteiner ind og ud af cellen. Dette system fungerer også som membranreserve, der sammen med det kontraktile cytoskelet gør trombocytten i stand til at øget sit overfladeareal op til fire gange ved blandt andet at udsende lange pseudopodier, der kan interagere med andre celler. Trombocyttens indre viskøse matrix indeholder desuden mikrotubuli, glykogendepoter, mitokondrier, resterende endoplasmatisk reticulum fra megakaryocytten, peroxisomer, lysosomer og to slags granula; 50-80 α-granula og 3-8 δ-granula pr. celle. Disse granula indeholder talrige proteiner og stoffer, der indgår i hæmostasen og frigives ved aktivering [4].
Arvelige trombocytsygdomme
Arvegangen ved arvelige trombocytsygdomme kan være autosomal recessiv, autosomal dominant, X-bunden eller endda kompleks med varianter i flere gener, der tilsammen resulterer i en klinisk blødningsfænotype [5]. Arvelige trombocytsygdomme er derfor en yderst heterogen gruppe, hvor den enkelte sygdom kan være meget sjælden, men den samlede prævalens er estimeret til 0,01%. Dette tal menes dog at være underestimeret [6], og ud fra populationsbaserede beregninger af loss of function-varianter i 58 trombocytassocierede gener er mindst 0,329% af den generelle befolkning prædisponerede til at have en arvelig trombocytsygdom [7].
Der er i dag identificeret mere end 60 forskellige gener associeret til arvelige trombocytsygdomme [8]. Nogle af disse gener har funktion i flere væv, og varianter heri kan være forbundet med syndromer, der rækker ud over det hæmostatiske system. De arvelige trombocytsygdomme kan inddeles i arvelige trombocytopenier (Tabel 1) og arvelige trombocytfunktionsdefekter (Tabel 2) med normalt trombocyttal. Begge kan være forbundet med syndromer, og arvelig trombocytopeni kan også være forbundet med andre sygdomme [9]. Blødningsfænotypen er mukokutan og omfatter blødninger fra slimhinder og hud, menoragi samt forlænget blødningstid ved kirurgi og fødsler. Blødningstendensen kan variere fra ingen blødning (isoleret mild trombocytopeni) til svær blødningstendens med livstruende blødningsepisoder [10].


I det følgende gennemgås et udvalg af arvelige trombocytsygdomme med kendt genetisk årsag. Bernard-Souliers syndrom (BSS) er karakteriseret ved manglende eller nedsat ekspression af glykoproteinkomplekset GPIb-IX-V, hvilket medfører defekt trombocytadhæsion og -aggregation. BSS er associeret til varianter i GP1BA, GP1BB eller GP9, der koder for hver deres underenhed af komplekset. Patienterne har trombocytopeni, makrotrombocytter (som kan være på størrelse med erytrocytter) i perifert udstryg og svær blødningstendens [11]. Glanzmanns trombasteni (GT) skyldes varianter i ITGA2B eller ITGB3, der koder for trombocyttens fibrinogenreceptor (GPIIb-IIIa), som medierer aggregation af aktiverede trombocytter. Patienterne har normalt trombocyttal og svær blødningstendens [12]. Gray platelet-syndrom er associeret til varianter i NBEAL og er karakteriseret ved grå og blege, »spøgelsesagtige« makrotrombocytter i perifert udstryg og manglende α-granula ved elektronmikroskopi. Blødningstendensen er varierende, og tilstanden kan være ledsaget af splenomegali, højt niveau af B12-vitamin, autoimmune lidelser og myelofibrose [13].
Sygdomme i relation til trombocyttens δ-granula indgår ofte i komplekse tilstande, hvor andre cellers organeller også er afficerede. Herunder kan nævnes Hermansky-Pudlaks syndrom, som er associeret til varianter i ti forskellige HPS-gener. Syndromet viser sig i form af albinisme, mild til moderat blødningstendens og evt. pulmonal fibrose, inflammatorisk tarmsygdom, neutropeni og immundefekt, afhængigt af typen [14]. Transkriptionsfaktordefekter i RUNX1, ETV6 og ANKRD26 medfører alle trombocytopeni og er forbundet med øget risiko for hæmatologisk malignitet [9]. Cytoskeletdefekten Wiskott-Aldrichs syndrom medfører X-bunden mikrotrombocytopeni med øget risiko for intrakranielle blødninger, eksem og immundefekt [10]. MYH-9-sygdomme er karakteriseret ved makrotrombocytopeni samt inklusionlegemer i leukocytterne (Döhle-legemer) og kan desuden vise sig i form af høretab, nyresvigt og katarakt [15].
Kliniske konsekvenser af korrekt diagnosticering
Livslang blødningstendens med gentagne mindre eller større blødninger samt kraftige menstruationer for kvinder kan have en stor indvirkning på patienternes livskvalitet [16], og de fleste patienter har et basalt behov for at kende årsagen til deres blødningstendens. Størstedelen af patienterne forbliver dog udiagnosticerede pga. manglende sygdomskendskab kombineret med manglende adgang til de nødvendige diagnostiske undersøgelser. Mange tilfælde bliver fejldiagnosticeret som immun trombocytopeni (ITP), og patienterne kan undergå unødvendig immunsupprimerende behandling, gentagne knoglemarvsundersøgelser eller endda splenektomi [9]. Det er dog essentielt at finde en korrekt diagnose for at kunne yde den optimale behandling. For MYH-9-associerede sygdomme kan iværksættelse af angiotensinkonverterende enzymhæmmer-behandling forebygge nyresvigt, og for patienter med øget risiko for hæmatologisk malignitet anbefales opfølgende blodprøvekontroller for at identificere udvikling af sekundær leukæmi. Kendskab til en sådan leukæmidisponerende variant kan desuden guide udvælgelsen af donor ved knoglemarvstransplantation. Ligeledes er viden om sygdommenes arvegange nødvendig for familierådgivning [17].
Udredning og diagnostik af arvelige trombocytsygdomme
Man bør få mistanke arvelig trombocytsygdom hos patienter der har: 1) livslang trombocytopeni og familiehistorik med trombocytopeni, myelodysplasi eller leukæmi, 2) familiehistorik med mukokutan blødningstendens uanset trombocyttal eller 3) en blødningstendens, der ikke er proportional med trombocyttallet [18]. Diagnostikken af arvelige trombocytsygdomme udgør dog en vedvarende udfordring, da mange af analyserne er dårligt standardiserede, teknisk udfordrende og har lav reproducerbarhed [19].
Det første skridt mod en diagnose (Figur 2) er en grundig klinisk evaluering af patienten. Sværhedsgraden af patientens blødningstendens vurderes ved hjælp af bleeding assessment tool (BAT)-score [20]. Patienten spørges grundigt ind til blødningssymptomer fra 14 forskellige lokationer og scores efter blødningsepisodernes alvorlighed og behov for behandling. En signifikant BAT-score er defineret som > 3 for mænd og > 5 for kvinder. Anamnesen bør derudover omfatte indtag af trombocythæmmende medicin og familiehistorik for blødning og hæmatologisk malignitet. Ved den kliniske undersøgelse vurderes blødningsmanifestationer (hæmatomer, petekkier mv.) samt tilstedeværelse af syndromiske præg. Ved fund af enten abnorm BAT-score og/eller klinisk undersøgelse laves en standardkoagulationsudredning.

Hvis standardudredningen er normal, bør patienten udredes for arvelig trombocytsygdom, hvor guldstandarden inkluderer perifert udstryg, lystransmissionsaggregometri (LTA) og flowcytometri [21]. Perifert udstryg kan give information om trombocytstørrelse og -morfologi. Vha. LTA vurderes trombocytfunktionen ved at måle transmissionen af lys igennem en suspension af trombocytter, som øges, når trombocytterne aggregerer i respons på stimulering med forskellige agonister [22]. Med flowcytometri er det muligt at måle ekspression af overfladeproteiner, indhold af α- og δ-granula og prokoagulant aktivitet [23]. Yderligere undersøgelser omfatter elektronmikroskopi til vurdering af strukturelle forandringer og α- og δ-granula indhold [21]. Sidste led i diagnostikken er genetisk udredning, som vi uddyber nedenfor.
Helgenomsekventering til diagnostik af arvelige trombocytsygdomme
Den hastige udvikling inden for sekventeringsteknologier har betydet, at man ved en helgenomanalyse (WGS) nu kan kortlægge alle tre milliarder basepar, som udgør en patients arvemasse, på mindre en uge. Tidligere anvendtes enkeltgenanalyser (Sangersekventering) eller genpaneler bestående af udvalgte gener. Fordelen ved at anvende WGS er, at varianter i genomets ikkekodende og regulatoriske områder også kan identificeres [24]. Patienter med arvelige trombocytsygdomme tilbydes i mange lande protokolleret udredning med WGS [5, 25, 26], hvilket vi også har gjort i Øresundsregionen siden 2015 [27]. Fremover bliver WGS-diagnostik af arvelige trombocytsygdomme muligt i både Øst- og Vestdanmark, idet arvelig hæmatologisk sygdom netop er udvalgt af Nationalt Genom Center (NGC: https://ngc.dk/) som en af de første sygdomsgrupper, hvor patienterne bør udredes via den nationale infrastruktur.
WGS-data filtreres til et opdateret in silico-genpanel, og til dette formål udgiver International Society of Thrombosis and Haemostasis (ISTH) årligt en opdateret liste over sygdomsdisponerende gener [8]. Når listen opdateres, er det altid muligt at reanalysere data og udvide antallet af gener og områder, der analyseres. Det er vigtigt, at patienten informeres grundigt om WGS-proceduren og de mulige konsekvenser af testresultatet. Alle identificerede varianter klassificeres i henhold til American College of Medical Genetics (ACMG) guidelines (klasse 1-5; 1: benign, 2: formodentlig benign, 3: ukendt betydning, 4: formodentlig patogen, 5: patogen) [28] og genotype-fænotype-forhold drøftes ved en multidisciplinær team (MDT) konference. Ved fund af klasse 3-varianter diskuteres mulige funktionelle undersøgelser, der kan bidrage til at bestemme den kliniske betydning af varianten.
WGS har markant forbedret det diagnostiske udfald for patienter med arvelige trombocytopenier, hvor en diagnose kan stilles hos ca. 50% [29, 30]. Hos patienter med et normalt trombocyttal er det dog kun omkring 10-20%, der opnår en diagnose [27]. Ved tilstedeværelse af veldefinerede syndromiske træk eller højtspecialiserede laboratorieanalyser forenelige med trombocytfunktionsdefekt, øges sandsynligheden for at opnå en diagnose [29]. Af denne grund er det vigtigt, at patienter, hvor man har mistanke om arvelig trombocytsygdom, henvises til højtspecialiserede centre.
Behandling
Generelt er de terapeutiske muligheder for behandling af blødningssymptomer ved arvelige trombocytsygdomme begrænsede og inkluderer desmopressin, trombocyttransfusioner, rekombinant FVIIa og antifibrinolytika. Resultatet af genetisk udredning har ikke på nuværende tidspunkt væsentlig betydning for den direkte blødningsbehandling.
Perspektiver
Implementering af WGS har revolutioneret diagnostikken af arvelige trombocytsygdomme ved at identificere stribevis af nye gener og derved muliggjort, at langt flere patienter kan få en specifik diagnose. På grund af de komplekse forhold vedrørende trombocytfunktionen er den genetiske baggrund dog fortsat ukendt for hovedparten af arvelige trombocytsygdomme. Der er derfor behov for at udbrede kendskabet til disse sygdomme og dele viden om nye genetiske varianter [8], så patienterne på sigt kan få målrettet behandling.
Korrespondance Nanna Brøns. E-mail: nanna.broens@regionh.dk
Antaget 24. juni 2021
Publiceret på ugeskriftet.dk 18. oktober 2021
Interessekonflikter ingen. Forfatternes ICMJE-formularer er tilgængelige sammen med artiklen på ugeskriftet.dk
Referencer findes i artiklen på ugeskriftet.dk
Artikelreference Ugeskr Læger 2021;183:V02210176
Referencer
-
Nurden AT, Freson K, Seligsohn U. Inherited platelet disorders. Haemophilia 2012;18(suppl 4):154-60.
-
Holinstat M. Normal platelet function. Cancer Metastasis Rev 2017;36:195-8.
-
Hoffman M, Monroe DM. A cell-based model of hemostasis. Thromb Haemost 2001;85:958-65.
-
Gremmel T, Frelinger AL 3rd, Michelson AD. Platelet physiology. Semin Thromb Hemost 2016;42:191-204.
-
Westbury SK, Turro E, Greene D et al. Human phenotype ontology annotation and cluster analysis to unravel genetic defects in 707 cases with unexplained bleeding and platelet disorders. Genome Med 2015;7:36.
-
Maclachlan A, Watson SP, Morgan NV. Inherited platelet disorders: Insight from platelet genomics using next-generation sequencing. Platelets 2017;28:14-9.
-
Oved JH, Lambert MP, Kowalska MA et al. Population based frequency of naturally occurring loss-of-function variants in genes associated with platelet disorders. J Thromb Haemost 2021;19:248-54.
-
Megy K, Downes K, Simeoni I et al. Curated disease-causing genes for bleeding, thrombotic, and platelet disorders: communication from the SSC of the ISTH. J Thromb Haemost 2019;17:1253-60.
-
Nurden AT, Nurden P. Inherited thrombocytopenias: history, advances and perspectives. Haematologica 2020;105:2004-19.
-
Bolton-Maggs PHB, Chalmers EA, Collins PW et al. A review of inherited platelet disorders with guidelines for their management on behalf of the UKHCDO. Br J Haematol 2006;135:603-33.
-
Savoia A, Kunishima S, De Rocco D et al. Spectrum of the mutations in bernard-soulier syndrome. Hum Mutat 2014;35:1033-45.
-
Nurden AT. Glanzmann thrombasthenia. Orphanet J Rare Dis 2006;1:10.
-
Pluthero FG, Di Paola J, Carcao MD, et al. NBEAL2 mutations and bleeding in patients with gray platelet syndrome. Platelets 2018;29:632-5.
-
Merideth MA, Introne WJ, Wang JA et al. Genetic variants associated with Hermansky-Pudlak syndrome. Platelets 2020;31:544-7.
-
Seri M, Pecci A, Di Bari F et al. MYH9-related disease. Medicine (Baltimore) 2003;82:203-15.
-
Presky KO, Kadir RA. Women with inherited bleeding disorders – challenges and strategies for improved care. Thromb Res 2020;196:569-78.
-
Downes K, Borry P, Ericson K et al. Clinical management, ethics and informed consent related to multi‐gene panel‐based high throughput sequencing testing for platelet disorders: Communication from the SSC of the ISTH. J Thromb Haemost 2020;18:2751-8.
-
Lambert MP. What to do when you suspect an inherited platelet disorder. Hematology Am Soc Hematol Educ Program 2011;2011:377-83.
-
Lassila R. Platelet function tests in bleeding disorders. Semin Thromb Hemost 2016;42:185-90.
-
Rodeghiero F, Tosetto A, Abshire T et al. ISTH/SSC bleeding assessment tool: a standardized questionnaire and a proposal for a new bleeding score for inherited bleeding disorders. J Thromb Haemost 2010;8:2063-5.
-
Gresele P, Harrison P, Gachet C et al. Diagnosis of inherited platelet function disorders: Guidance from the SSC of the ISTH. J Thromb Haemost 2015;13:314-22.
-
Cattaneo M, Cerletti C, Harrison P et al. Recommendations for the standardization of light transmission aggregometry: a consensus of the working party from the platelet physiology subcommittee of SSC/ISTH. J Thromb Haemost 2013;11:1183-9.
-
Vinholt PJ, Frederiksen H, Hvas A-M et al. Measurement of platelet aggregation, independently of patient platelet count: a flow-cytometric approach. J Thromb Haemost 2017;15:1191-202.
-
Simeoni I, Stephens JC, Hu F et al. A high-throughput sequencing test for diagnosing inherited bleeding, thrombotic, and platelet disorders. Blood 2016;127:2791-803.
-
Bastida JM, Lozano ML, Benito R et al. Introducing high-throughput sequencing into mainstream genetic diagnosis practice in inherited platelet disorders. Haematologica 2018;103:148-62.
-
Johnson B, Lowe GC, Futterer J et al. Whole exome sequencing identifies genetic variants in inherited thrombocytopenia with secondary qualitative function defects. Haematologica 2016;101:1170-9.
-
Leinøe E, Zetterberg E, Kinalis S et al. Application of whole-exome sequencing to direct the specific functional testing and diagnosis of rare inherited bleeding disorders in patients from the Öresund Region, Scandinavia. Br J Haematol 2017;179:308-22.
-
Richards S, Aziz N, Bale S et al. Standards and guidelines for the interpretation of sequence variants: a joint consensus recommendation of the American College of Medical Genetics and Genomics and the Association for Molecular Pathology. Genet Med 2015;17:405-24.
-
Downes K, Megy K, Duarte D et al. Diagnostic high-throughput sequencing of 2396 patients with bleeding, thrombotic, and platelet disorders. Blood 2019;134:2082-91.
-
Leinøe E, Gabrielaite M, Østrup O et al. Outcome of an enhanced diagnostic pipeline for patients suspected of inherited thrombocytopenia. Br J Haematol 2019;186:373-6.
Nanna Brøns, Maria Rossing & Eva Birgitte Leinøe
Ugeskr Læger 2021;183:V02210176
Inherited platelet disorders (IPD) cover a heterogenous group of disorders with large differences in severity, disease mechanisms and prevalence. Pathogenic variants in more than 60 different genes, associated with megakaryocyte or platelet number and/or function, are causal of IPD. Due to disease heterogeneity IPDs are often difficult to diagnose, problematic to manage and underestimated. In the past decade, genetic diagnostics using whole-genome sequencing has revolutionised the field by identifying numerous novel genes involved in IPD aetiology as described in this review.